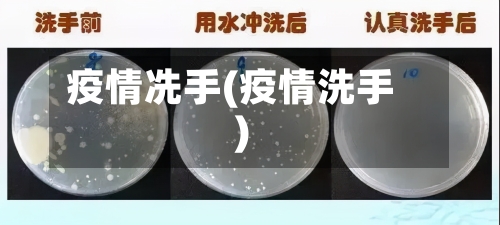
疫情冼手(疫情洗手)-第2张图片

云南近来可以去旅游,且有多种游玩方式可供选取。游玩方式多样结伴游:存在6天5晚的结伴游行程 ,费用1000多,性价比相对较高 。

云南作为中国热门旅游目的地,整体旅游环境是安全的 ,但跟团游的安全性需结合具体情况来看。以下从多个维度为您分析:基础设施与治安云南主要旅游城市(昆明、大理 、丽江等)治安良好,景区安保完善。2023年云南重点景区已实现监控全覆盖,游客密集区设有警务亭 。
现在去云南大理旅游整体是安全的。大理作为热门旅游城市 ,旅游业发达,主要旅游区域治安良好,景区安保措施完善,多数当地人和商家友善热情。2023年云南重点景区已实现监控全覆盖 ,游客密集区设有警务亭,进一步保障了旅游安全 。
去云南旅游是相对安全的,但需要提前做好充分的准备和规划 ,了解当地的风俗习惯、气候特点和安全注意事项,选取正规的旅游渠道和产品,避免前往高风险地区 ,同时在旅行过程中要保持警惕,注意个人财物安全和人身安全。
外地人可以前往云南旅游。近来,云南对外地游客开放 ,但游客需要提供48小时内的核酸检测阴性证明。在旅行期间,游客应遵守当地的防疫政策,注意个人防护 。 云南的居民也可以前往外省。只要车辆手续齐全 ,云南牌照的车辆可以开往中国其他省份。不过,长途驾驶需要注意车况检查,避免疲劳驾驶,确保安全 。
〖壹〗、篇一:小学生永远跟党走奋进新征程征文800字 周一下午的队会课 ,张校长给我们上了“从小学党史,永远跟党走 ”的党史课。张校长讲得绘声绘色,我听得津津有味 ,学会了很多知识!首先,张校长给大家讲了两个一百年的内容。
〖贰〗 、奋进新征程建功新时代主题征文一 昂首不畏千夫指,开天辟地担己任 。一百多年前 ,马克思主义如一声惊雷,惊醒多少中国人!李大钊同志作为中国共产党的创始人之一,敢于做第一个吃螃蟹的人 ,不畏质疑的目光,在国内率先介绍、传播马克思主义。他的著作《我的马克思主义观》为中国共产党提供了强有力的理论支撑。
〖叁〗、雷锋一心向党,把党比作“母亲” ,作为“儿子”,无论遇到怎样艰难复杂的情况,都“坚决听党的话,一辈子跟党走 ” ,“对党 、对人民忠诚坦白 。”他爱憎分明不忘本,立场坚定斗志强,全心全意为人民服务。
〖肆〗、新时代好少年强国有我征文1 妈妈说梁启超先生的《读书指南》里列了23本书 ,说如果这些书都没有读过就不能认为是中国学人。列的第一本就是《四书》,于是假期的时候,妈妈先让我读了大学中庸和论语 ,并且让我背诵了一部分 。 论语里有两句我记得格外清楚。
〖伍〗、小时候,外婆告诉我没有您就没有新中国,听党话跟党走征文800字【优秀篇】。长大后 ,妈妈告诉我没有您就没有今天的幸福安康。今天的我沐浴在党的阳光下,一路前行,唱着赞美您的歌……暑假 ,我来到了家乡红色爱国主义教育基地——溧阳水西村江南指挥部 。岁月的沧桑,创就了革命的水西。
〖陆〗、始终保持对党绝对忠诚 、对党的事业绝对忠诚,以赤诚之忠心来感恩组织的培养与信任,以神圣之使命来履行组织赋予自己的职责使命。始终做到在党言党、在党爱党、在党忧党 、在党为党 ,以党的理论和路线方针政策为前进方向,不忘初心、牢记使命,感党恩听党话 ,永远跟党走 。
手足口病疫苗是需要打的,原因如下:EV71病毒感染风险高且后果严重研究表明,EV71病毒是导致手足口病重症和死亡的主要病原体。儿童在5-11月龄时母传抗体水平最低 ,而手足口病的高发年龄为6月龄至2岁,此阶段儿童免疫系统尚未完善,感染风险显著增加。
接种必要性:若孩子处于6月龄至3岁 ,建议尽早接种,以降低重症和死亡风险 。若孩子已超过3岁,且未接种过该疫苗 ,可询问医生是否补种(但重症风险随年龄增长降低,补种意义可能有限)。
建议为≥6月龄易感儿童接种国产手足口病疫苗(EV71疫苗),尤其是12月龄前完成接种,以预防EV71感染导致的重症手足口病及相关死亡。手足口病的危害与疫苗必要性疾病严重性:手足口病由多种肠道病毒引起 ,其中EV71病毒是导致重症和死亡的主要病原体 。
手足口病疫苗有必要接种,主要原因如下: 预防严重感染与并发症手足口病主要由肠道病毒引起,其中EV71病毒是导致重症病例的核心病原体。感染EV71后 ,患儿可能出现高热、肺炎 、心肌炎,甚至神经源性肺水肿等严重并发症。这些并发症可能引发多器官功能衰竭,威胁儿童生命安全 。
手足口病疫苗不是必须打的。以下是对此观点的详细解释:疫苗性质:手足口病EV71灭活疫苗属于二类疫苗 ,这意味着它不是国家计划免疫程序内的疫苗,而是按照知情、自愿、自费的原则接种。家长有权根据孩子的实际情况和自身意愿,决定是否让孩子接种该疫苗。
截至2月16日24时 ,黑龙江省报告新型冠状病毒感染的肺炎确诊病例457例,其中:哈尔滨市188例 、双鸭山市50例、鸡西市46例、绥化市46例 、齐齐哈尔市42例、大庆市20例、七台河市16例、佳木斯市15例 、黑河市14例、牡丹江市12例、鹤岗市5例 、大兴安岭地区2例、伊春市1例;现有重症病例73例 。
每天量体温,并且上报班主任。了解掌握一些自我保护的常识 ,比如:不到处走、不聚会 、勤洗手、戴口罩等。有条件的同学可以在家进行网上学习,条件不允许的同学可复习旧知识 。记得要合理安排作息时间,适当运动,注意用眼卫生。了解疫情的真实情况 ,对于疫情不恐忙、不信谣 、不传谣。
外出归来、饭前便后、咳嗽打喷嚏后,都应及时洗手 。洗手时,需使用流动水 ,同时要用肥皂或洗手液仔细揉搓手上的每个部位。少去人多且密闭的场所,避免接触感染。不走亲访友,不与有呼吸道感染症状的人接触 。如必须外出 ,要正确佩戴口罩,做好防护措施。
所以第一步要提升孩子的体质,增强他们自身的抵抗力。一个良好的体质 ,能够有效的抵御病毒的侵害 。在平时要注意培养孩子良好的行为习惯,引导他们积极锻炼强身健体,孩子拥有一个良好的体魄。注意防护 ,接种疫苗 很多人担心疫苗的安全性,不敢让孩子接种疫苗。
勤洗手。教孩子使用七步洗手法,勤洗手可以有效减少病毒和细菌滋生 。 多通风。教室环境相对封闭,可以多通风 ,增加空气流通。 及时消杀 。每天放学后或者上学前做好预防性消杀,预防病毒。
疫情面前,儿童由于年龄较小 ,抵抗力弱,是传染性疾病的高危人群,因此需要格外用心的呵护。家长朋友要帮助孩子建立良好的生活习惯 ,提高儿童的防护意识,下面让我们共同学习一下儿童新冠肺炎的防控要点吧 。
